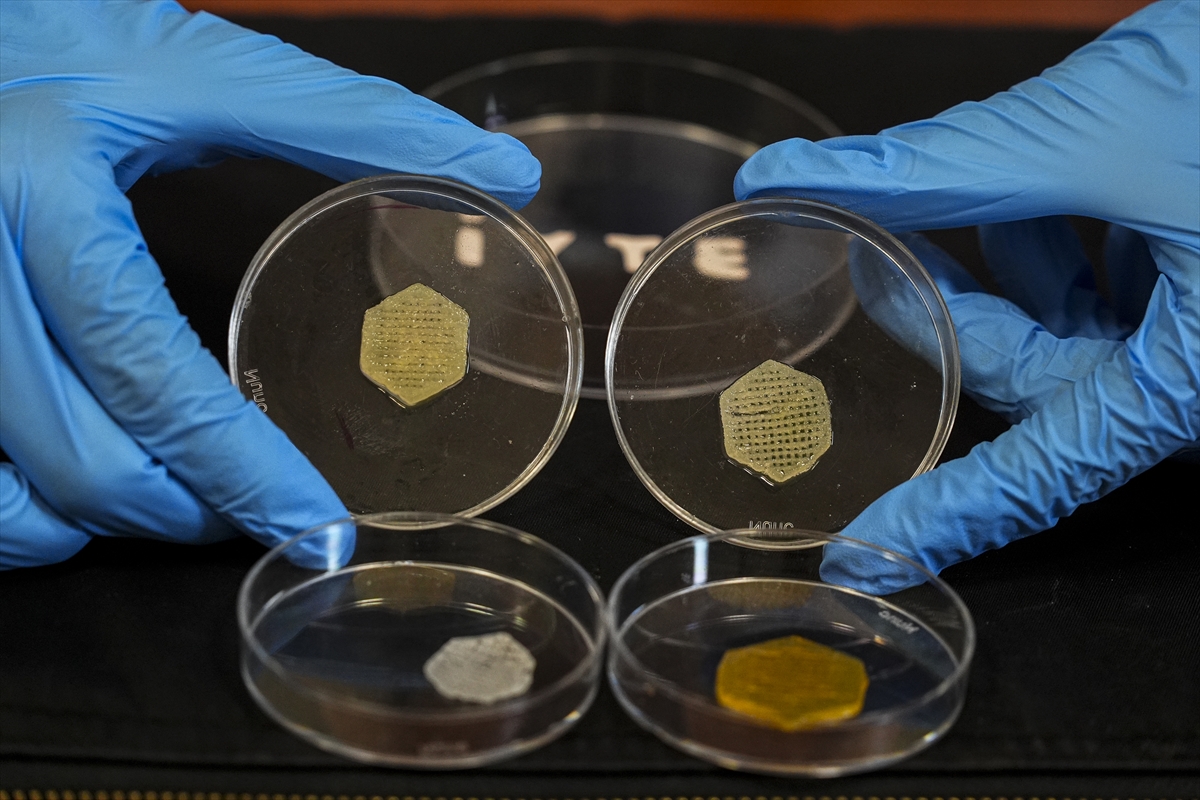
Klasik Yara Bantları Tarihe Karışıyor. İzmir’den Probiyotikli Devrim4

İzmir Yüksek Teknoloji Enstitüsü (İYTE) Fen Fakültesi Kimya Bölümü Öğretim Üyesi Doç. Dr. Seda Kehr ve ekibi, diyabetik ülser ve yanık gibi kronik yaraların tedavi sürecini desteklemek amacıyla yaklaşık iki yıl önce İYTE Biyomedikal Mikro ve Nano Sistemler Laboratuvarı’nda proje çalışmalarına başladı.
Yoğun laboratuvar sürecinin ardından geliştirilen “Oksijen Taşıyıcı, Esansiyel Yağ ve Probiyotik Metabolitler İçeren Canlı Bir Hidrojel Bazlı Yara Örtüsü” başlıklı ürün, Türk Patent ve Marka Kurumu tarafından tescil edildi.

Klasik yara bandından farklı
Doç. Dr. Seda Kehr, geliştirilen sistemin farklı bileşenlerin bir araya gelmesiyle sinerjik etki oluşturacak şekilde tasarlandığını belirtti. Ürünün esansiyel yağlarla zenginleştirildiğini ifade eden Kehr, en önemli özelliğinin probiyotik içermesi ve oksijen salınımı yapabilen nano parçacıklara sahip olması olduğunu kaydetti. Yara örtüsünün ilk etapta deri hastalıklarında kullanılması planlanırken, enjekte edilebilir formu sayesinde vücut içindeki yaralara da uygulanabilme potansiyeli taşıdığı belirtildi.
Farklı formlarda uygulanabiliyor
Ürünün yalnızca klasik bir yara bandı formunda tasarlanmadığını aktaran Kehr, hidrojel yapının püskürtülebilir, jel olarak uygulanabilir ve üç boyutlu yazıcı ile kişiye özel boyutlarda üretilebilir özellikte olduğunu ifade etti. Bu sayede hastaların yara tipine ve büyüklüğüne göre özel tasarım yapılabileceği bildirildi.

Probiyotiklerle kontrollü iyileşme
Probiyotiklerin faydalı bakteriler olduğunu vurgulayan Kehr, bu bakterilerin yara iyileşme sürecine katkı sağlamak amacıyla kapsülleme yöntemiyle korunduğunu belirtti. Bu yöntemle hem faydalı metabolitlerin kontrollü salınımının sağlandığını hem de probiyotiklerin canlılığının korunduğunu ifade etti.

Laboratuvar aşamasında bakteri ve hücre testlerinin tamamlandığını kaydeden Kehr, bir sonraki aşamada hayvan deneyleri ve klinik çalışmaların planlandığını açıkladı. Ürünün ilk etapta yarayı destekleyici formuyla piyasaya sunulması hedeflenirken, vücut içine uygulanabilecek biyomalzeme formunun klinik sürecinin daha uzun süreceği belirtildi.












